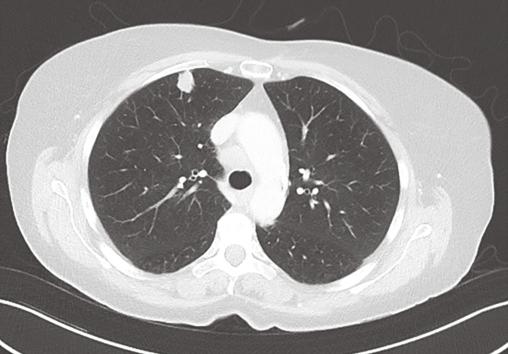
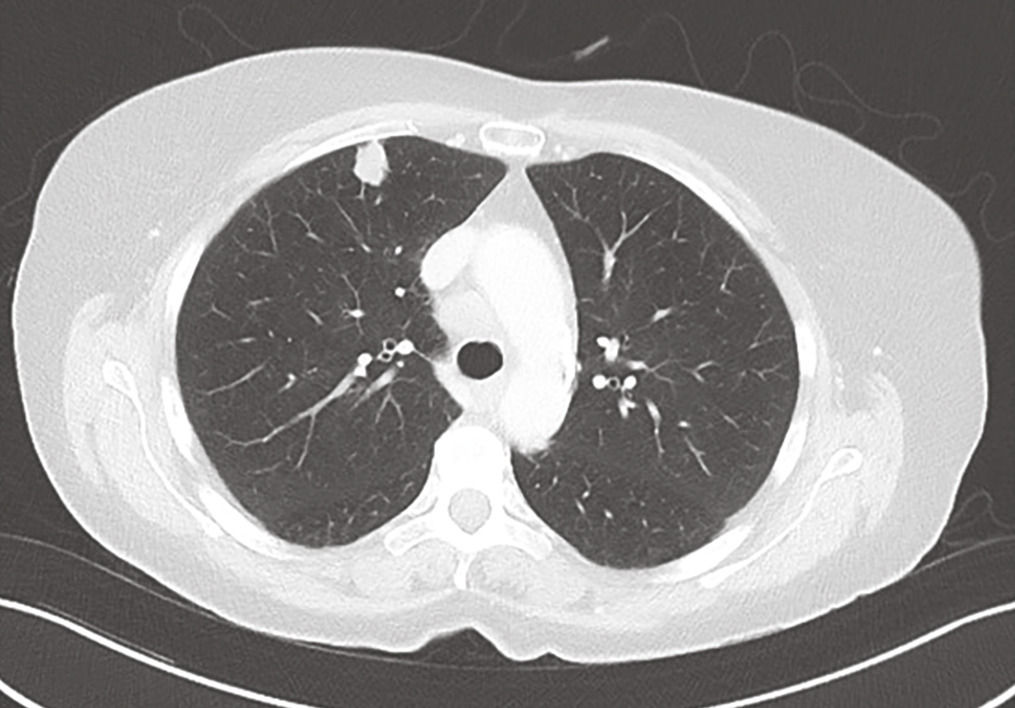

Une femme de 70 ans, tabagique sevrée à 45 paquets-années, présente un syndrome médullaire d’évolution rapide (3 semaines). L’imagerie par résonance magnétique montre une masse fusiforme intramédullaire au niveau de C7 (fig. 1 ). Le bilan lésionnel met en évidence un nodule pulmonaire évocateur de lésion néoplasique primitive (fig. 2 ), et plusieurs autres lésions secondaires : cérébrale, ganglionnaires et hépatiques. La biopsie hépatique confirme le diagnostic de carcinome pulmonaire (marqueur TTF-1 positif) métastatique peu différencié. L’évolution rapidement progressive a conduit à la mise en place de soins palliatifs exclusifs.
Les lésions médullaires sont de trois types :1 extradurales (osseuses rachidiennes), intradurales extramédullaires (méningiome, schwannome ou neurofibrome), ou intramédullaires (épendymome, astrocytome ou hémangioblastome).
Les métastases intramédullaires sont rares. Les cancers pulmonaires et du sein en sont les principaux pourvoyeurs.2, 3 Elles constituent la première manifestation du cancer dans 10 à 25 % des cas.2, 4 L’évolution rapide de l’atteinte neurologique est en faveur du diagnostic de métastase intramédullaire.2 Le pronostic est sombre, avec une médiane de survie de trois à quatre mois.2,3,4 Devant la rareté des métastases intramédullaires, le traitement n’est pas encore codifié et dépend de la nature du cancer primitif. La résection chirurgicale peut être réalisée sur les lésions isolées.4 La radiothérapie constitue une alternative thérapeutique.3 Ces deux options ont un effet modéré sur la survie des patients.
Les métastases intramédullaires sont rares. Les cancers pulmonaires et du sein en sont les principaux pourvoyeurs.2, 3 Elles constituent la première manifestation du cancer dans 10 à 25 % des cas.2, 4 L’évolution rapide de l’atteinte neurologique est en faveur du diagnostic de métastase intramédullaire.2 Le pronostic est sombre, avec une médiane de survie de trois à quatre mois.2,3,4 Devant la rareté des métastases intramédullaires, le traitement n’est pas encore codifié et dépend de la nature du cancer primitif. La résection chirurgicale peut être réalisée sur les lésions isolées.4 La radiothérapie constitue une alternative thérapeutique.3 Ces deux options ont un effet modéré sur la survie des patients.
Références
1. Duong LM, McCarthy BJ, McLendon RE, Dolecek TA, Kruchko C, Douglas LL, et al. Descriptive epidemiology of malignant and nonmalignant primary spinal cord, spinal meninges, and cauda equina tumors, United States, 2004-2007. Cancer 2012;118(17):4220‑7.
2. Schiff D, O’Neill BP. Intramedullary spinal cord metastases: Clinical features and treatment outcome. Neurology 1996;47(4):906‑12.
3. Lv J, Liu B, Quan X, Li C, Dong L, Liu M. Intramedullary spinal cord metastasis in malignancies: An institutional analysis and review. Onco Targets Ther 2019;12:4741-53.
4. Goyal A, Yolcu Y, Kerezoudis P, Alvi MA, Krauss WE, Bydon M. Intramedullary spinal cord metastases: An institutional review of survival and outcomes. J Neurooncol 2019;142(2):347-54.
2. Schiff D, O’Neill BP. Intramedullary spinal cord metastases: Clinical features and treatment outcome. Neurology 1996;47(4):906‑12.
3. Lv J, Liu B, Quan X, Li C, Dong L, Liu M. Intramedullary spinal cord metastasis in malignancies: An institutional analysis and review. Onco Targets Ther 2019;12:4741-53.
4. Goyal A, Yolcu Y, Kerezoudis P, Alvi MA, Krauss WE, Bydon M. Intramedullary spinal cord metastases: An institutional review of survival and outcomes. J Neurooncol 2019;142(2):347-54.
Une question, un commentaire ?